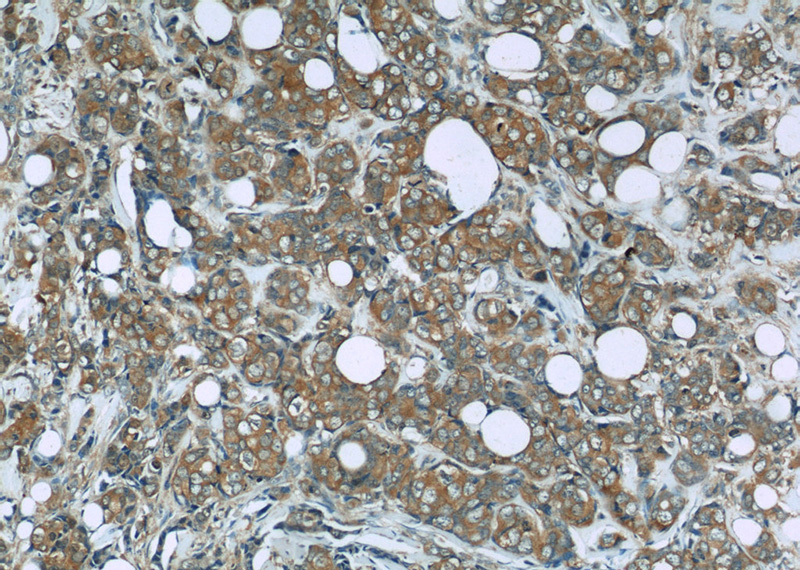
Immunohistochemistry of paraffin-embedded human breast cancer slide using Catalog No:114175(PRDX1 Antibody) at dilution of 1:50

-
Product Name
PRDX1 antibody
- Documents
-
Description
PRDX1 Rabbit Polyclonal antibody. Positive IP detected in HeLa cells. Positive WB detected in HEK-293 cells, A549 cells, HeLa cells, MCF7 cells, mouse kidney tissue, NIH/3T3 cells, Raji cells, rat kidney tissue, RAW 264.7 cells. Positive IF detected in HepG2 cells, RAW 264.7 cells. Positive IHC detected in human breast cancer tissue, human brain tissue. Positive FC detected in HepG2 cells. Observed molecular weight by Western-blot: 23 kDa
-
Tested applications
ELISA, WB, IF, IHC, IP, FC
-
Species reactivity
Human, Mouse, Rat; other species not tested.
-
Alternative names
MSP23 antibody; NKEF A antibody; NKEFA antibody; PAG antibody; PAGA antibody; PAGB antibody; peroxiredoxin 1 antibody; PRDX1 antibody; PRX1 antibody; PRXI antibody; TDPX2 antibody; Thioredoxin peroxidase 2 antibody
-
Isotype
Rabbit IgG
-
Preparation
This antibody was obtained by immunization of PRDX1 recombinant protein (Accession Number: NM_002574). Purification method: Antigen affinity purified.
-
Clonality
Polyclonal
-
Formulation
PBS with 0.02% sodium azide and 50% glycerol pH 7.3.
-
Storage instructions
Store at -20℃. DO NOT ALIQUOT
-
Applications
Recommended Dilution:
WB: 1:500-1:5000
IP: 1:500-1:5000
IHC: 1:20-1:200
IF: 1:10-1:100
-
Validations

HEK-293 cells were subjected to SDS PAGE followed by western blot with Catalog No:114175(PRDX1 antibody) at dilution of 1:1000
Immunohistochemistry of paraffin-embedded human breast cancer slide using Catalog No:114175(PRDX1 Antibody) at dilution of 1:50

Immunohistochemistry of paraffin-embedded human breast cancer slide using Catalog No:114175(PRDX1 Antibody) at dilution of 1:50

Immunofluorescent analysis of HepG2 cells using Catalog No:114175(PRDX1 Antibody) at dilution of 1:25 and Rhodamine-Goat anti-Rabbit IgG

IP Result of anti-PRDX1 (IP:Catalog No:114175, 3ug; Detection:Catalog No:114175 1:1000) with HeLa cells lysate 2400ug.

1X10^6 HepG2 cells were stained with 0.2ug PRDX1 antibody (Catalog No:114175, red) and control antibody (blue). Fixed with 90% MeOH blocked with 3% BSA (30 min). Alexa Fluor 488-congugated AffiniPure Goat Anti-Rabbit IgG(H+L) with dilution 1:1500.
-
Background
PRDX1(Peroxiredoxin-1) is a thiol reductase that plays critical roles in oxidative and thermal stress defense mechanisms through its abilities to metabolize H2O2 and act as a molecular chaperone, respectively.PRDX1 also reduces intramolecular cystine bridges .It can form a dimer(PMID:22583657).It also can be phosphorylated on Thr-90 during the M-phase, which leads to a more than 80% decrease in enzymatic activity(PMID:11986303).
-
References
- Zhao X, Cong X, Zheng L, Xu L, Yin L, Peng J. Dioscin, a natural steroid saponin, shows remarkable protective effect against acetaminophen-induced liver damage in vitro and in vivo. Toxicology letters. 214(1):69-80. 2012.
- Liu C, Zhang A, Guo J. Identification of human host proteins contributing to H5N1 influenza virus propagation by membrane proteomics. Journal of proteome research. 11(11):5396-405. 2012.
- Wu H, Xiao Y, Zhang S. The Ets transcription factor GABP is a component of the hippo pathway essential for growth and antioxidant defense. Cell reports. 3(5):1663-77. 2013.
- Liu C, Lin JJ, Yang ZY, Tsai CC, Hsu JL, Wu YJ. Proteomic study reveals a co-occurrence of gallic acid-induced apoptosis and glycolysis in B16F10 melanoma cells. Journal of agricultural and food chemistry. 62(48):11672-80. 2014.
Related Products / Services
Please note: All products are "FOR RESEARCH USE ONLY AND ARE NOT INTENDED FOR DIAGNOSTIC OR THERAPEUTIC USE"
